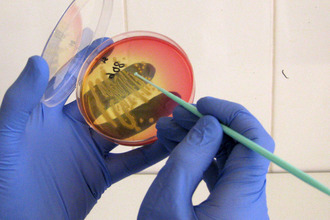

Ангина – причины и симптомы
Ангина у детей: причины, виды и способы заражения
Ангина, или острый тонзиллит, — это инфекционное заболевание, характеризующееся острым воспалением лимфаденоидной ткани глоточных миндалин. У детей чаще всего страдают небные миндалины, или гланды, которые располагаются на границе ротовой полости и глотки.
Если ангина у ребенка не лечится должным образом, она может перейти в хроническую стадию, известную как хронический тонзиллит.
Наиболее опасным возбудителем тонзиллита является бета-гемолитический стрептококк группы А, который может вызывать фолликулярную или лакунарную ангину. Также ангина может быть вызвана золотистым стафилококком. Некоторые вирусы, такие как аденовирус, также могут вызывать ангину, при этом внешние проявления будут схожи со стрептококковой ангиной.
Существует три основных типа ангин, различающихся по причинам возникновения:
-
Эпизодическая ангина — возникает редко у здоровых детей при неблагоприятных условиях. К внешним факторам, способствующим развитию ангины, относятся переохлаждение, нехватка витаминов, употребление холодных напитков или блюд. Возбудителем выступает условно-патогенная микрофлора слизистой оболочки (например, стафилококк), активирующаяся при снижении иммунитета.
-
Эпидемическая ангина — возникает в результате заражения от больного человека. Возбудителями могут быть вирусы ОРВИ, стрептококк и другие микроорганизмы, передающиеся от человека к человеку.
-
Обостряющаяся ангина — проявление хронического тонзиллита. Симптомы обострения менее выражены, чем при остром тонзиллите, и могут появляться периодически после переохлаждения или ОРВИ.
Как происходит заражение? Исследования показывают, что возбудители могут попасть в ротовую полость двумя основными путями:
- Воздушно-капельным путем — при разговоре на близком расстоянии, поцелуях, использовании общей посуды и т.д.
- Алиментарным путем (фекально-оральным) — при недостаточном соблюдении правил личной гигиены после посещения туалета и перед едой, что часто наблюдается у детей в детских садах, школах и лагерях.
В большинстве случаев источником инфекции является человек, страдающий ангиной. Также возможны случаи заражения от бессимптомных носителей инфекции.
Существует несколько форм ангины, различающихся как по внешним проявлениям, так и по причинам. Поэтому лечение каждого типа ангины требует индивидуального подхода. Рассмотрим подробнее наиболее распространенные из них.
Врачи отмечают, что ангина у детей является распространённым заболеванием, которое требует внимательного подхода. По их мнению, основными симптомами являются боль в горле, высокая температура и общее недомогание. Специалисты подчеркивают важность своевременной диагностики, так как неправильное лечение может привести к осложнениям, таким как ревматизм или гломерулонефрит. Врачи рекомендуют родителям не заниматься самолечением и обращаться за медицинской помощью при первых признаках заболевания. Лечение может включать антибиотики, если ангина вызвана бактериальной инфекцией, а также симптоматическую терапию для облегчения состояния ребенка. Важно также обеспечить ребенку достаточное количество жидкости и покой для скорейшего выздоровления.

Катаральный тонзиллит
Катаральная форма тонзиллита — наиболее распространенная как среди детей, так и среди взрослых. У детей острый катаральный тонзиллит обычно протекает легче, чем другие формы этого заболевания.
Основные симптомы катарального тонзиллита:
- ощущение сухости во рту;
- першение в горле;
- болезненные ощущения при глотании;
- покраснение миндалин;
- прозрачный слизистый налет на миндалинах;
- головная боль;
- температура до 38°C (у старших детей может оставаться в пределах нормы).
Инкубационный период ангины у детей составляет от 1 до 4 дней. Вспышки заболевания часто фиксируются в детских коллективах, таких как школы или детские сады. Обычно катаральная форма начинается с умеренного повышения температуры, общего недомогания и слабости. Грудные дети могут проявлять сопротивление при кормлении, становясь капризными и беспокойными. Старшие дети чаще всего жалуются на боль в горле и головную боль. Не игнорируйте эти симптомы — начните лечение как можно скорее.
В большинстве случаев возбудителями катаральной формы тонзиллита являются вирусы.
Эту форму заболевания можно вылечить без антибиотиков.
Лечение катаральной ангины в основном включает местные процедуры. Миндалины обрабатывают антисептическими средствами в виде спреев (рекомендуется избегать мазей, таких как Люголь, так как они могут травмировать миндалины и усугубить состояние). Важно полоскать горло антисептическими растворами — это помогает уменьшить налет на миндалинах и предотвращает развитие вторичной бактериальной инфекции. Дети старше 6 лет могут самостоятельно полоскать горло и использовать спрей, однако для детей младше 5 лет эти процедуры должны проводиться под контролем взрослых.
Не забывайте о простых дополнительных мерах лечения, таких как обильное теплое питье, проветривание комнаты больного и сбалансированное питание с витаминами. При выборе фруктов лучше отдавать предпочтение мягким и некислым плодам. Следует избегать пищи очень низкой или высокой температуры, а также пряных, острых и соленых блюд, так как они могут раздражать воспаленные ткани и усиливать боль.
При катаральной форме, в отличие от гнойной, можно применять сухое тепло на шею и согревающие напитки.
| Симптом | Возможная причина | Что делать |
|---|---|---|
| Высокая температура (выше 38°C) | Инфекция (вирусная или бактериальная) | Дать жаропонижающее (парацетамол или ибупрофен) по возрасту, обеспечить обильное питье |
| Боль в горле | Воспаление миндалин | Полоскание горла (если ребенок умеет), прохладные напитки, обезболивающие спреи/леденцы (по возрасту) |
| Отек миндалин | Инфекция, аллергическая реакция | Обратиться к врачу |
| Налет на миндалинах (белый, желтый) | Бактериальная инфекция (часто стрептококковая) | Обратиться к врачу для анализа и назначения антибиотиков |
| Трудности с глотанием | Боль в горле, отек | Предложить мягкую пищу, обильное питье |
| Слабость, вялость | Интоксикация организма | Постельный режим, обильное питье |
| Головная боль | Интоксикация, воспаление | Обеспечить отдых, жаропонижающее при высокой температуре |
| Рвота | Интоксикация, сильная боль | Обратиться к врачу |
Лакунарная и фолликулярная формы — сходства и отличия
Лакунарный тонзиллит
Лакунарный тонзиллит проявляется более выраженными симптомами, чем катаральная форма заболевания.
Заподозрить болезнь можно при сильной боли в горле и повышении температуры до 40°С. У детей заболевание часто сопровождается тошнотой, а в некоторых случаях — рвотой.
Температура при лакунарной форме трудно поддается снижению. Жаропонижающие средства лишь временно помогают, так как инфекция продолжает развиваться. Применение антибиотиков позволяет нормализовать температуру уже на второй день болезни.
Одним из характерных признаков лакунарного тонзиллита является образование гнойного налета в лакунах миндалин. Налет белого цвета может иметь желтоватый или зеленоватый оттенок и рыхлую текстуру.
Гнойные осложнения лакунарной ангины у детей могут включать бактериальный конъюнктивит, круп (отек мягких тканей горла, угрожающий удушением) и острый отит (воспаление среднего уха).
Фолликулярная ангина
Внешние проявления фолликулярной ангины схожи с симптомами лакунарной формы. Однако фарингоскопический осмотр позволяет легко различить эти два типа заболевания.
При фолликулярной ангине миндалины выглядят как «звездное небо» из-за множества мелких гнойничков на их поверхности.
Важно отметить, что как фолликулярная, так и лакунарная ангина у детей практически не встречаются до 4 лет. Это связано с тем, что миндалины не полностью развиты до 5 лет, и бактерии их обычно не поражают. Если у ребенка младше 4 лет болит горло, скорее всего, у него фарингит — воспаление слизистой оболочки глотки.
Лечение
Гнойные формы ангины могут перейти в хроническую стадию, поэтому важно правильно и своевременно их лечить. С первых дней болезни необходимо соблюдать постельный режим и много отдыхать. Рекомендуется часто полоскать горло (5-7 раз в день), чтобы уменьшить количество гноя и очистить лакуны от остатков пищи. После полоскания горло можно обработать антисептиком в виде спрея (до 4 раз в день).
Местное лечение улучшает общее состояние пациента, но не устраняет инфекцию. Для полного выздоровления необходимо воздействовать на причину — микроорганизм-возбудитель.
Фолликулярная и лакунарная формы ангины возникают из-за бактериальной инфекции, поэтому их лечение обязательно включает прием антибиотиков.
Антибиотикотерапия не только помогает быстро снизить температуру и облегчить другие симптомы, но и предотвращает гнойные и ревматические осложнения, вызванные стрептококковой инфекцией.
Стрептококки, вызывающие воспаление миндалин, в основном чувствительны к антибиотикам группы пенициллинов, поэтому первым выбором является «Амоксициллин» или его аналоги. Для лечения маленьких детей удобно использовать антибиотики в форме порошка или суспензии — их легче проглотить.
Если у ребенка есть склонность к аллергическим реакциям или возбудитель болезни нечувствителен к пенициллинам, назначают антибактериальные препараты макролидной группы, такие как «Клацид», «Цефалексин», «Сумамед», «Эритромицин» и другие.
Курс лечения ангины у детей составляет 7-10 дней, в зависимости от выбранного препарата. Существуют антибиотики, которые можно принимать в течение 5 дней, но в более высокой дозировке. Симптомы могут исчезнуть быстрее, однако это не является основанием для преждевременного прекращения лечения — для предотвращения рецидива антибиотик следует принимать столько дней, сколько указано в инструкции.
Дозировку препарата для ребенка, особенно младше 5 лет, необходимо рассчитывать не по возрасту, а по весу.
По завершении курса лечения рекомендуется сдать клинические анализы мочи и крови, чтобы удостовериться в отсутствии возможных осложнений.
Ангина у детей — это распространенное заболевание, которое вызывает много беспокойства у родителей. Многие отмечают, что симптомы, такие как боль в горле, высокая температура и общее недомогание, могут проявляться внезапно. Родители часто делятся опытом, как важно не игнорировать эти признаки и обращаться к врачу для диагностики. Некоторые рассказывают о том, как их дети страдали от ангины несколько раз за год, что заставляло их задумываться о профилактике. Многие рекомендуют следить за гигиеной, укреплять иммунитет и избегать контактов с больными. Также часто упоминается о важности своевременного лечения, чтобы избежать осложнений. В целом, обсуждение ангины у детей подчеркивает необходимость внимательного отношения к здоровью и быстрого реагирования на первые симптомы.

Герпетическая ангина
Герпетическая ангина, или герпангина, — это заболевание, чаще всего встречающееся у детей в возрасте от 1 до 7 лет, хотя иногда может затрагивать и более старших. Это типично детская болезнь, и после перенесенного заболевания у человека формируется стойкий иммунитет на всю жизнь.
Несмотря на название, герпангину вызывает не вирус герпеса, а энтеровирус Коксаки. Этот вирус поражает слизистую оболочку горла и кишечника, что приводит к характерным симптомам:
- резкое повышение температуры (до 38-39 °C, а у детей младшего возраста — до 41 °C);
- сильная боль в горле, усиливающаяся при глотании и разговоре;
- снижение аппетита из-за дискомфорта при приеме пищи;
- отек и покраснение слизистой глотки, мягкого неба, миндалин и языка;
- образование пузырьков в горле, заполненных прозрачной жидкостью, которые могут лопаться и вызывать язвы (иногда раны напоминают гнойнички, что может ввести родителей в заблуждение и заставить думать, что это фолликулярная ангина);
- боли в животе;
- тошнота и рвота.
Герпетическая ангина у детей может протекать тяжело, но обычно имеет хороший прогноз. В течение 6-7 дней иммунная система справляется с вирусом, и у ребенка формируется длительный иммунитет к этому заболеванию. Лечение герпангины в основном симптоматическое: оно направлено на улучшение общего состояния и предотвращение вторичного инфицирования язвочек в горле. В терапию входят полоскания горла, орошение антисептиками и обильное питье. Важно соблюдать постельный режим на протяжении всего периода лечения.
Что делать, если болезнь не поддается лечению?
Ангина у детей может возникать по различным причинам и иметь разную степень тяжести. Однако при своевременном обращении к врачу заболевание обычно проходит быстро (в течение 4-7 дней) и без осложнений. Если ангина у ребенка плохо поддается лечению, это может указывать на три возможные ситуации:
- неверный диагноз, что приводит к назначению неэффективных препаратов;
- наличие устойчивого штамма микроорганизма;
- хроническая форма заболевания.
Чтобы исключить первый вариант, достаточно провести дополнительные исследования: бактериологический посев мазка из горла, общий анализ крови и определение титра АСЛО (антител к стрептококку). Результаты этих анализов помогут врачу определить, какой микроорганизм вызывает заболевание.
Если вы уверены, что у ребенка бактериальная ангина, но антибиотик не дает результата, это может означать, что микроорганизм устойчив к назначенному препарату. Устойчивость проявляется, если температура не снижается на третий день приема антибиотиков.
В таком случае следует заменить антибиотик на другой, относящийся к иной группе антибактериальных средств. Определить наиболее эффективный антибиотик поможет тот же бактериологический посев мазка из горла.
Хроническая форма заболевания диагностируется, если обострения тонзиллита происходят 5 и более раз в год. При хроническом тонзиллите требуется более интенсивное лечение, обычно с использованием мощных антибиотиков в повышенных дозах на протяжении 5-14 дней. Однако даже в этом случае не всегда удается полностью устранить инфекцию. В таких ситуациях может потребоваться хирургическое удаление миндалин, что позволяет избавиться от источника инфекции и снизить риск развития ревматизма. Операция проводится только в крайних случаях, так как лимфоидная ткань миндалин выполняет важные иммунные и кроветворные функции.

Вопрос-ответ
Как быстро лечится ангина у детей?
Бактериальная ангина лечится только антибиотиками, которые назначает врач. Стандартный курс антибактериальной терапии составляет 10 дней. Облегчение на фоне лечения наступает достаточно быстро, ребенок чувствует себя лучше и уже через день после приема антибиотика перестает быть заразным для окружающих.
Как понять, что у ребенка ангины?
Чтобы понять, что у ребенка ангина, обратите внимание на такие симптомы, как высокая температура, боль в горле, затрудненное глотание, покраснение и отек миндалин, а также наличие белых или желтых налетов на них. Также могут наблюдаться общая слабость, головная боль и увеличение лимфатических узлов. Если вы заметили эти признаки, рекомендуется обратиться к врачу для подтверждения диагноза и назначения лечения.
Сколько дней болеют ангиной дети?
Прогноз ангины у детей. Вирусная ангина проходит самостоятельно в среднем за 7–14 дней. Прогноз в обоих случаях благоприятный.
Советы
СОВЕТ №1
Обратите внимание на симптомы. При ангине у детей могут проявляться такие признаки, как боль в горле, высокая температура, затрудненное глотание и общее недомогание. Если вы заметили эти симптомы, не откладывайте визит к врачу.
СОВЕТ №2
Обеспечьте ребенку комфортные условия. Убедитесь, что он получает достаточно жидкости и отдыхает. Теплые напитки, такие как чай с медом или отвар шиповника, могут помочь облегчить боль в горле.
СОВЕТ №3
Следите за гигиеной. Ангина может быть заразной, поэтому важно обучить ребенка правилам личной гигиены: мыть руки перед едой и после посещения туалета, а также избегать близкого контакта с другими детьми во время болезни.
СОВЕТ №4
Не занимайтесь самолечением. При ангине важно правильно установить диагноз и назначить лечение. Не давайте ребенку антибиотики без назначения врача, так как это может привести к осложнениям и развитию устойчивости к лекарствам.